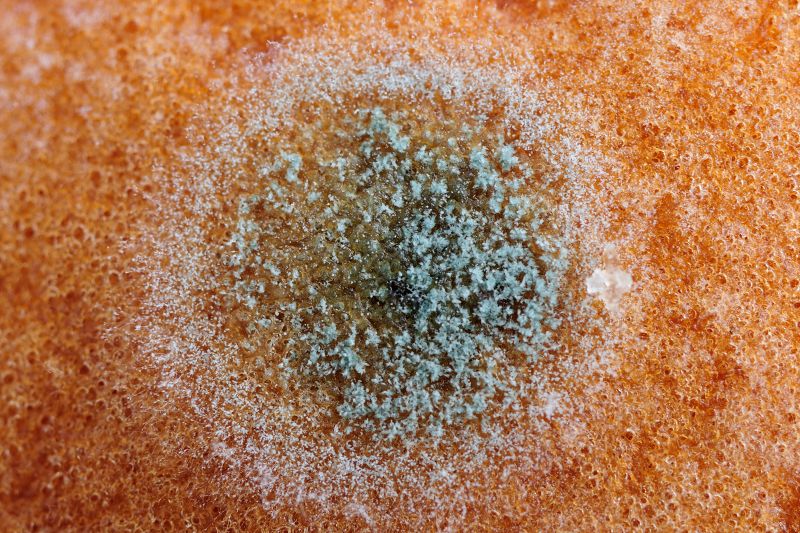
파일:bread02 010.jpg

bread02 010.jpg
Maintenance script (토론 | 기여)님의 2019년 4월 29일 (월) 11:23 판
미리 보기 크기: 800 × 533 픽셀 다른 해상도: 320 × 213 픽셀 | 1,600 × 1,066 픽셀
원본 파일 (1,600 × 1,066 픽셀, 파일 크기: 1.76 MB, MIME 종류: image/jpeg)
파일의 설명
Importing file
파일 역사
날짜/시간 링크를 클릭하면 해당 시간의 파일을 볼 수 있습니다.
| 날짜/시간 | 섬네일 | 크기 | 사용자 | 설명 | |
|---|---|---|---|---|---|
| 현재 | 2019년 4월 29일 (월) 11:23 |  | 1,600 × 1,066 (1.76 MB) | Maintenance script (토론 | 기여) |
- 이 파일을 덮어쓸 수 없습니다.